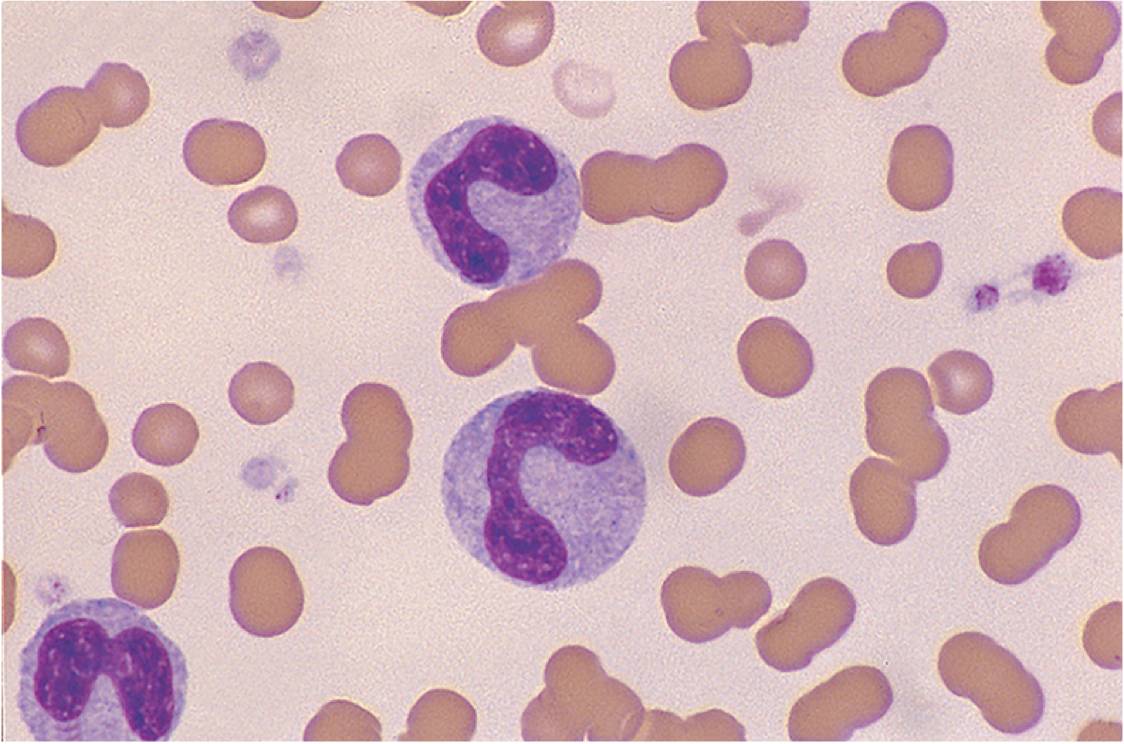

Dr. Alma Calavera
Dr. Alma Calavera
NEW CONTACT DETAILS!!! CALL ***0947 8914048 *** for (Virtual/Tele Consultation) or **0915 3201001 for (Face to Face Consultation) Dra. Calavera is a practicing Adult Hematologist specializing in Bone Marrow Transplant dealing with Cancers and Diseases of the Blood and Bone Marrow
Loading description...
Adult Hematology
21 Years
Bleeding Disorders and Blood Dyscracias
Blood Diseases
Bone Marrow Transplant, Cellular Therapy, Leukemia, Lymphoma
Cancer of the Blood and Bone Marrow
Transfusion Medicine
In-Person
Online





Choose from 4 available clinics

Thursday and Saturday
12:00 PM - 06:00 PM
Thursday
01:00 PM - 03:00 PM
Fee: P 700 - 1000

Monday to Wednesday, Friday
01:00 PM - 05:00 PM
(By Appointment)
call 09153201001
Fee: -
Saturday
04:30 PM - 05:00 PM
(By Appointment)
Fee: -

Thursday
02:00 PM - 04:00 PM
(By Appointment)
Fee: -

